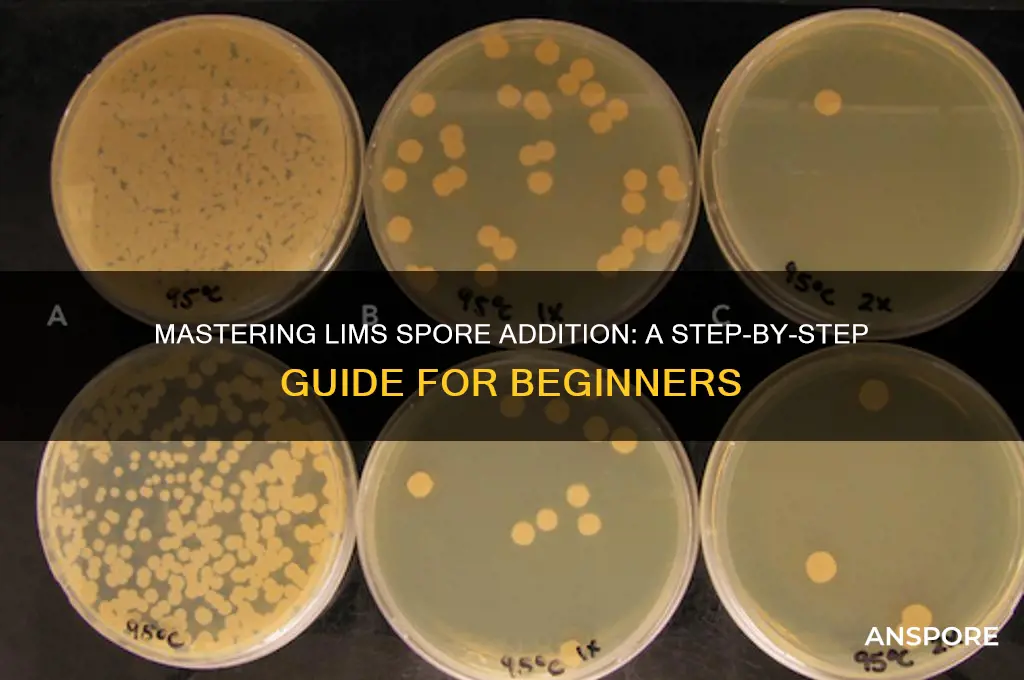
how to add lims spore

Adding LIMS (Laboratory Information Management System) spore data is a critical process in microbiology and quality control workflows, ensuring accurate tracking and analysis of spore samples. To begin, users must first configure the LIMS system to accept spore-specific data fields, such as spore type, concentration, and viability. Next, samples are prepared and analyzed according to standardized protocols, with results manually or automatically entered into the LIMS interface. Integration with laboratory instruments, such as spore counters or viability testers, can streamline data entry and reduce errors. Once recorded, the LIMS system enables efficient data management, allowing for trend analysis, compliance reporting, and traceability of spore samples throughout their lifecycle. Proper training for laboratory personnel and adherence to data validation procedures are essential to ensure the integrity and reliability of the spore data within the LIMS framework.
| Characteristics | Values |
|---|---|
| Purpose | To introduce a specific strain of bacteria (likely Bacillus subtilis var. natto) into a fermentation process, typically for producing traditional foods like natto. |
| Spore Source | Commercially available LIMS (Laboratory Information Management System) spores or spores isolated from existing natto cultures. |
| Sterilization | Spores are heat-resistant, but equipment and ingredients must be sterilized to prevent contamination. |
| Activation | Spores require activation before use, often involving heat shock or specific nutrient conditions. |
| Inoculation Rate | The amount of spores added depends on the desired fermentation outcome and recipe. Typically a small percentage of the total substrate. |
| Fermentation Conditions | Controlled temperature (around 40°C), humidity, and time are crucial for successful spore germination and fermentation. |
| Monitoring | pH, temperature, and visual inspection are used to monitor fermentation progress. |
| Safety | Proper hygiene and handling practices are essential to prevent contamination and ensure food safety. |
Explore related products
What You'll Learn
- Prepare Spore Suspension: Sterilize spores, suspend in sterile water, adjust concentration, and store properly for future use
- Sterilize Equipment: Autoclave tools, clean workspace, and ensure aseptic conditions to prevent contamination during addition
- Measure Spore Concentration: Use hemocytometer or spectrophotometer to accurately determine spore density before adding to LIMS
- Record Data in LIMS: Input spore details, concentration, and metadata into the LIMS system for tracking
- Validate Addition: Confirm spore integration, check for errors, and ensure compliance with lab protocols in LIMS

Prepare Spore Suspension: Sterilize spores, suspend in sterile water, adjust concentration, and store properly for future use
Spores, with their remarkable resilience, are essential in various scientific applications, from microbiology research to quality control in food and pharmaceuticals. However, their durability also necessitates careful handling to ensure purity and viability. Preparing a spore suspension is a critical step in many laboratory protocols, and it begins with sterilization.
The Sterilization Imperative: Before introducing spores into any experiment, eliminating contaminants is paramount. Heat sterilization, typically at 121°C for 15-20 minutes in an autoclave, is the gold standard. This process effectively kills vegetative cells and most microorganisms, leaving behind only the heat-resistant spores. For heat-sensitive spores, alternative methods like filtration through 0.22 μm filters or exposure to UV radiation can be employed, though these methods require meticulous validation to ensure complete sterilization.
Suspension and Dilution: Once sterilized, spores are suspended in sterile distilled water or a suitable buffer solution. The choice of solvent depends on the intended application. For instance, phosphate-buffered saline (PBS) is often used for maintaining spore viability during storage. The initial suspension should be gently vortexed to ensure even distribution of spores. Subsequent dilutions are crucial for achieving the desired spore concentration. Serial dilutions, typically in tenfold increments, are performed using sterile diluents. Each dilution step should be carefully pipetted and mixed to maintain accuracy.
Concentration Control: Determining the spore concentration is vital for experimental reproducibility. Direct counting using a hemocytometer or a more sophisticated technique like flow cytometry provides an accurate estimate. Alternatively, plating serial dilutions onto agar plates and counting colonies after incubation offers a traditional but reliable method. The target concentration varies depending on the application. For example, spore suspensions used in antibiotic susceptibility testing typically range from 10^5 to 10^6 CFU/mL, while environmental monitoring may require lower concentrations.
Storage Strategies: Proper storage is essential to preserve spore viability. Short-term storage (up to a week) can be achieved at 4°C in sterile tubes. For long-term storage, freezing at -20°C or below is recommended. Adding glycerol (15-20%) to the suspension acts as a cryoprotectant, preventing damage during freezing and thawing. It's crucial to label stored suspensions with the spore type, concentration, date of preparation, and storage conditions. Regular viability checks are recommended, especially for long-term storage, to ensure the spores remain viable for future experiments.
Discovering Mushroom Spores: A Beginner's Guide to Collection and Cultivation
You may want to see also

Sterilize Equipment: Autoclave tools, clean workspace, and ensure aseptic conditions to prevent contamination during addition
Contamination is the silent saboteur of any lims spore addition process. A single rogue microbe can compromise your entire experiment, rendering results unreliable. To thwart this invisible enemy, sterilization becomes your most potent weapon. Autoclaving, the gold standard for sterilization, employs steam under pressure (typically 121°C and 15 psi for 15-30 minutes) to obliterate bacteria, fungi, and their spores. This brutal yet effective method ensures your tools—pipettes, culture dishes, and any other equipment coming into contact with your lims spores—are free from biological intruders.
However, autoclaving is just the first line of defense. Your workspace demands equal attention. Imagine a battlefield where, despite having sterilized weapons, the ground itself is riddled with enemy soldiers. Cleanliness is not merely aesthetic; it’s strategic. Use 70% ethanol or a suitable disinfectant to wipe down surfaces, paying special attention to areas where tools will rest or where you’ll handle the lims spores. Allow sufficient drying time to prevent chemical residue from interfering with your experiment. A cluttered workspace is a contamination magnet, so organize your area to minimize dust and debris.
Aseptic technique is the final, critical layer in your defense. Think of it as the discipline of movement and handling in a sterile environment. Always flame-sterilize inoculating loops or needles before and after use, allowing them to cool momentarily to avoid killing your lims spores. Work near a flame or under a laminar flow hood to create a sterile air curtain. Minimize talking, coughing, or any action that could introduce airborne contaminants. Wear lab coats, gloves, and masks to reduce the risk of shedding skin cells or hair into your workspace.
Consider this scenario: You’ve autoclave-sterilized your pipette, cleaned your workspace meticulously, and donned your aseptic gear. Yet, you absentmindedly place the pipette on an unsterilized bench. Contamination strikes. Such oversights highlight the importance of mindfulness and consistency in every step. Sterilization is not a one-time act but a continuous practice, demanding vigilance from start to finish.
In conclusion, sterilizing equipment, cleaning the workspace, and maintaining aseptic conditions form an interconnected system of safeguards. Each step, when executed with precision, fortifies your experiment against contamination. Skimp on any one, and you risk undermining the entire process. Treat sterilization not as a chore but as a ritual—a meticulous, deliberate practice that ensures the integrity of your lims spore addition. Your results will thank you.
Can Bacteria Form Spores? Unveiling Microbial Survival Strategies
You may want to see also

Measure Spore Concentration: Use hemocytometer or spectrophotometer to accurately determine spore density before adding to LIMS
Accurate spore concentration measurement is critical before adding samples to a Laboratory Information Management System (LIMS). Two primary methods dominate this process: the hemocytometer and the spectrophotometer. Each offers distinct advantages and limitations, making the choice dependent on specific experimental needs and available resources.
A hemocytometer, a manual counting chamber, provides a direct and visually verifiable count of spores under a microscope. This method is ideal for low-concentration samples or when precise enumeration is crucial. To use, dilute the spore suspension appropriately, load the hemocytometer, and count spores within the designated grid areas. Multiply the average count by the dilution factor to obtain the concentration. While labor-intensive, this method ensures accuracy and allows for visual confirmation of spore morphology.
Spectrophotometers, on the other hand, offer a faster, high-throughput alternative. They measure light absorbance at a specific wavelength, correlating it to spore concentration based on a pre-established standard curve. This method is suitable for high-volume samples and provides rapid results. However, it relies on the assumption that spore size and composition remain consistent, and may be less accurate for mixed populations or samples with debris.
Calibration is paramount for both methods. For hemocytometers, ensure the grid lines are clearly visible and the counting area is free of scratches. For spectrophotometers, establish a reliable standard curve using known spore concentrations and regularly calibrate the instrument.
Ultimately, the choice between hemocytometer and spectrophotometer depends on the specific requirements of the experiment. For precise enumeration and morphological analysis, the hemocytometer excels. For high-throughput screening and rapid results, the spectrophotometer is the preferred choice. Regardless of method, accurate spore concentration measurement is fundamental to ensuring data integrity and reliable results within the LIMS framework.
Unlocking Spore's Brain Surgeon Badge: A Step-by-Step Guide
You may want to see also
Explore related products

Record Data in LIMS: Input spore details, concentration, and metadata into the LIMS system for tracking
Accurate data entry is the cornerstone of effective spore tracking in a Laboratory Information Management System (LIMS). When recording spore details, precision is paramount. Begin by inputting the spore type, using standardized nomenclature to ensure consistency across the database. For instance, *Bacillus subtilis* or *Aspergillus niger* should be entered exactly as they appear in your reference materials. Concentration data, typically measured in colony-forming units per milliliter (CFU/mL), must be recorded with decimal precision—e.g., 1.2 × 10⁶ CFU/mL. Avoid rounding unless explicitly instructed, as even minor discrepancies can skew downstream analysis.
Metadata enriches your spore records, providing context that enhances traceability and usability. Include details such as the date and time of sample collection, the source (e.g., air, water, soil), and the method of isolation. For environmental samples, note conditions like temperature (25°C) or humidity (60%) at the time of collection. If the spore is part of a larger study, link it to the relevant project ID or batch number. This metadata transforms raw data into actionable insights, enabling researchers to identify trends or anomalies in spore behavior.
The process of inputting data into LIMS requires a systematic approach to minimize errors. Start by verifying the sample ID against the physical label to ensure accuracy. Use dropdown menus or predefined templates where available to reduce manual entry and standardize inputs. For concentration values, double-check units and significant figures before submission. If your LIMS supports automated calculations, leverage this feature to derive metrics like viability or growth rates directly from raw data. Always save entries immediately to prevent data loss and maintain an audit trail for compliance purposes.
One common pitfall in spore data recording is overlooking the importance of versioning. If a sample undergoes multiple analyses or updates, ensure each iteration is timestamped and linked to the original record. This preserves historical data while reflecting current findings. For example, if a spore concentration is re-evaluated after storage, log the new value alongside the initial measurement, noting the storage duration (e.g., 30 days at 4°C). This practice ensures transparency and supports reproducibility in research.
Finally, consider the end-user when structuring your LIMS entries. Researchers, quality control teams, and regulatory bodies may all access this data, so clarity and completeness are critical. Include notes on any deviations from standard protocols or unusual observations during sample processing. For instance, if a spore suspension was agitated for 10 minutes instead of the usual 5, document this detail. By prioritizing thoroughness and organization, you ensure that your LIMS data remains a reliable resource for all stakeholders.
Are Spores Alive? Exploring the Living Nature of Spores
You may want to see also

Validate Addition: Confirm spore integration, check for errors, and ensure compliance with lab protocols in LIMS
After adding spore data to your LIMS, the critical next step is validation. This process ensures the integrity of your laboratory’s data and maintains compliance with regulatory standards. Begin by confirming spore integration—verify that the spore count, type, and metadata (e.g., source, date collected) are accurately reflected in the system. Cross-reference the LIMS entry with the original lab notebook or digital record to ensure no discrepancies exist. For instance, if you’ve added a *Bacillus subtilis* spore sample with a concentration of 10^6 CFU/mL, check that the LIMS displays this exact value and not a rounded or misinterpreted figure.
Errors in data entry can compromise experimental outcomes and regulatory audits. Common pitfalls include typos in sample IDs, incorrect units (e.g., CFU/mL vs. CFU/g), or missing fields like incubation conditions. Implement a dual-check system where a second technician reviews the entry before finalization. Automated validation tools within LIMS can also flag inconsistencies, such as a spore viability percentage exceeding 100% or a sample date postdating the analysis. Address these errors immediately, documenting corrections in an audit trail to maintain traceability.
Compliance with lab protocols is non-negotiable, especially in regulated industries like pharmaceuticals or food safety. Ensure the spore addition aligns with internal SOPs and external guidelines (e.g., ISO 11133 for microbial quality control). For example, if your lab requires spores to be stored at -20°C before analysis, confirm this condition is noted in the LIMS. Similarly, if a specific dilution series (e.g., 1:10, 1:100) is mandated, verify that the LIMS reflects the correct dilution factor and method. Deviations from protocol must be justified and approved by a supervisor, with documentation linked to the LIMS record.
Practical tips can streamline the validation process. Create a checklist tailored to your lab’s spore analysis workflow, including fields like sample ID, spore type, concentration, storage conditions, and analyst initials. Train staff to use LIMS features like batch validation for multiple entries or customizable alerts for incomplete records. For high-stakes samples, consider a third-party audit or peer review to ensure compliance. By treating validation as a proactive step rather than a formality, you safeguard data accuracy and uphold the credibility of your lab’s work.
Post-Winter Leaf Mold: Are Spores Lurking in Your Garden?
You may want to see also
Frequently asked questions
LIMS (Laboratory Information Management System) spore refers to the integration of spore testing or tracking functionalities into a LIMS. It’s important because it helps laboratories efficiently manage spore testing data, ensure compliance with regulatory standards, and streamline workflows for better accuracy and traceability.
To add LIMS spore functionality, check if your current LIMS offers customizable modules or integrations for spore testing. If not, consult your vendor for add-ons or upgrades. Alternatively, consider migrating to a LIMS platform that supports spore testing natively.
Essential data fields include spore type, batch/lot number, expiration date, test results (e.g., positive/negative), incubation conditions, and technician notes. Ensure your LIMS captures these fields for comprehensive tracking and reporting.
Yes, many LIMS platforms allow automation of spore testing workflows, such as scheduling tests, recording results, and generating alerts for failed tests. Automation reduces manual errors and improves efficiency.
Ensure your LIMS meets regulatory requirements (e.g., ISO, FDA, or CLIA) by validating the spore testing module, maintaining audit trails, and regularly updating the system to comply with industry standards. Consult with compliance experts if needed.































